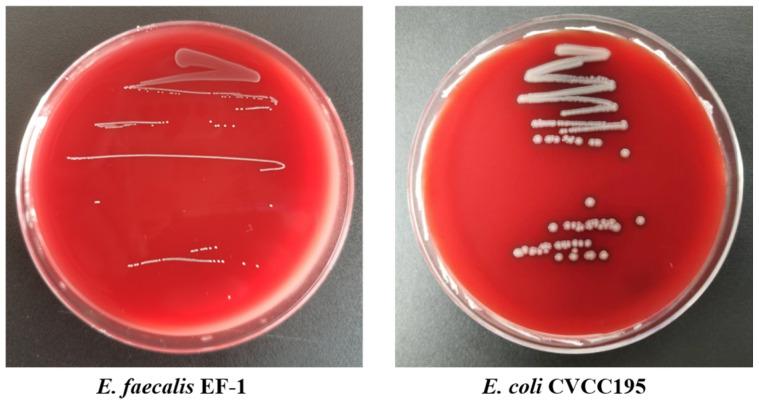
https://cdn.ncbi.nlm.nih.gov/pmc/blobs/53be/11675756/35f4255ec70c/foods-13-04095-g002.jpg

高脂饮食喂养小鼠中益生菌EF-1活性及抗肥胖作用的体外评价
In Vitro Evaluation of Probiotic Activities and Anti-Obesity Effects of EF-1 in Mice Fed a High-Fat Diet.
作者信息
Cai Hongying, Wang Qingya, Han Xiling, Zhang Haiou, Wang Na, Huang Yuyin, Yang Peilong, Zhang Rui, Meng Kun
机构信息
Key Laboratory of Feed Biotechnology of Ministry of Agriculture and Rural Affairs, Institute of Feed Research, Chinese Academy of Agricultural Sciences, Beijing 100081, China.
Key Laboratory of Yunnan for Biomass Energy and Biotechnology of Environment, Yunnan Normal University, Kunming 650500, China.
出版信息
Foods. 2024 Dec 18;13(24):4095. doi: 10.3390/foods13244095.
This research sought to assess the anti-obesity potential of EF-1. An extensive and robust in vitro methodology confirmed EF-1's significant potential in combating obesity, probably due to its excellent gastrointestinal tract adaptability, cholesterol-lowering property, bile salt hydrolase activity, α-glucosidase inhibition, and fatty acid absorption ability. Moreover, EF-1 exhibited antimicrobial activity against several pathogenic strains, lacked hemolytic activity, and was sensitive to all antibiotics tested. To further investigate EF-1's anti-obesity properties in vivo, a high-fat diet (HFD) was used to induce obesity in C57BL/6J mice. Treatment with EF-1 (2 × 10 CFU/day) mitigated HFD-induced body weight gain, reduced adipose tissue weight, and preserved liver function. EF-1 also ameliorated obesity-associated microbiota imbalances, such as decreasing the / ratio and boosting the levels of bacteria (, , , , and _NK4A136_group), which are responsible for the generation of short-chain fatty acids (SCFAs). Concurrently, the levels of total SCFAs were elevated. Thus, following comprehensive safety and efficacy assessments in vitro and in vivo, our results demonstrate that EF-1 inhibits HFD-induced obesity through the regulation of gut microbiota and enhancing SCFA production. This strain appears to be a highly promising candidate for anti-obesity therapeutics or functional foods.
本研究旨在评估EF-1的抗肥胖潜力。广泛且可靠的体外实验方法证实了EF-1在对抗肥胖方面具有显著潜力,这可能归因于其出色的胃肠道适应性、降胆固醇特性、胆汁盐水解酶活性、α-葡萄糖苷酶抑制作用以及脂肪酸吸收能力。此外,EF-1对几种致病菌株表现出抗菌活性,缺乏溶血活性,并且对所有测试的抗生素敏感。为了进一步研究EF-1在体内的抗肥胖特性,采用高脂饮食(HFD)诱导C57BL/6J小鼠肥胖。用EF-1(2×10 CFU/天)治疗可减轻HFD诱导的体重增加,降低脂肪组织重量,并保护肝功能。EF-1还改善了与肥胖相关的微生物群失衡,例如降低/比值并提高负责产生短链脂肪酸(SCFA)的细菌(、、、和_NK4A136_组)的水平。同时,总SCFA水平升高。因此,在体外和体内进行全面的安全性和有效性评估后,我们的结果表明EF-1通过调节肠道微生物群和增强SCFA产生来抑制HFD诱导的肥胖。该菌株似乎是抗肥胖治疗或功能性食品的极有前景的候选者。